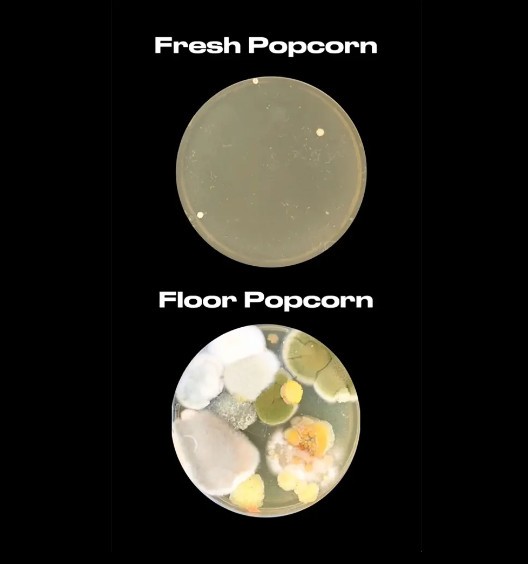
fbadfbafb.jpg

Μικροβιολόγος μας κάνει να ξεχάσουμε τον «κανόνα των 5 δευτερολέπτων»
Διαβάστε σχετικά
- Κατερίνη: Είχε όγκο στο δεξί νεφρό, αλλά του αφαίρεσαν το αριστερό
- Απογευματινά χειρουργεία: Ανατροπή με τις αμοιβές των γιατρών
- Πόσο μας παχαίνει ο γάμος; Ποιοι παίρνουν τα περισσότερα κιλά
- Έρευνα: Το junk food σκοτώνει όπως το κάπνισμα, προκαλεί από λευχαιμία μέχρι έμφραγμα
- ΗΠΑ: Έχασε 95 κιλά σε δύο χρόνια με αυτή την επικίνδυνη δίαιτα – Ο συγκινητικός λόγος που το έκανε